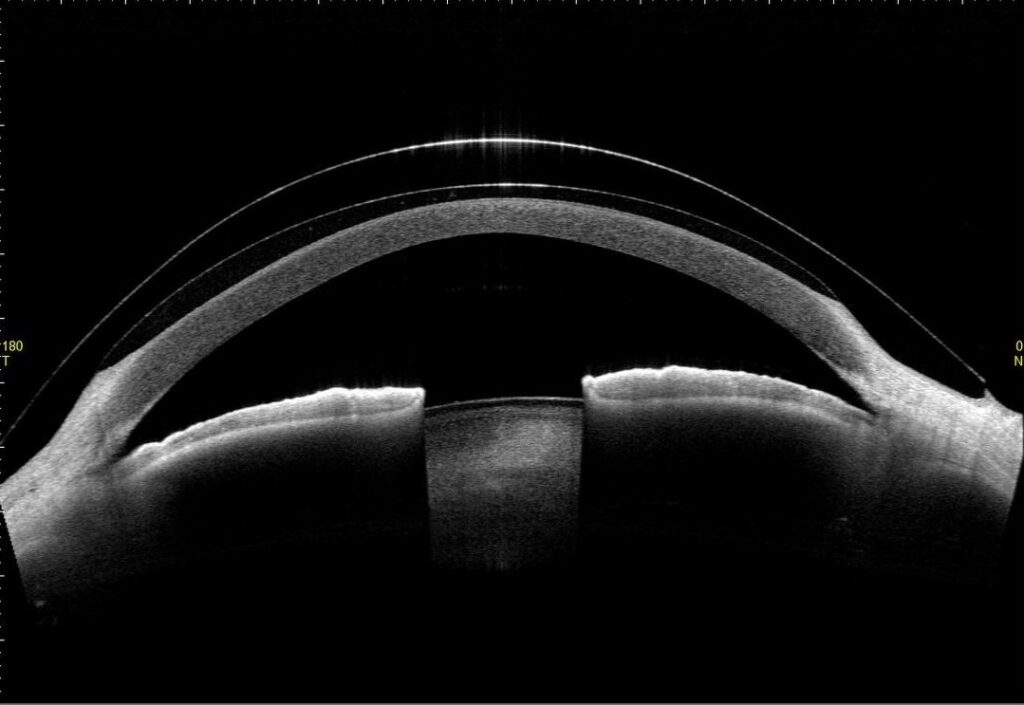

東京都中央区のオルソケラトロジー専門外来・自由診療
京橋いしづち眼科では眼表面や近視に対する専門外来を設け、自由診療を提案しています
近視抑制外来
近視は、近い距離にあるものはよく見えますが、遠い距離のものが見えにくい状態です。
子供の近視は、主に眼球が楕円形に伸びてしまう(眼軸長が伸びる)ことで、生じることが多いです。近くを見ることが習慣化してしまうと近視になりやすく、一度眼軸長が伸びてしまうと戻ることがありません。そのために眼軸長の伸びを抑えることが、近視の進行を抑制するためには重要となります。

オルソケラトロジーレンズ治療
オルソケラトロジーレンズは近視および近視性乱視の角膜に、特殊なデザインのハードコンタクトレンズを就寝時に装用することで、角膜の形状を一定期間変形させ、日中裸眼で過ごせるようにする視力矯正治療です。スポーツをされる方にもオルソケラトロジーレンズは向いています。
最近ではオルソケラトロジーレンズの「近視抑制効果」も注目されています。近視があるお子さんへの近視抑制効果が期待されています。安全性に関しては、国内で臨床試験の結果、安全性が評価され認可されたものですのでご安心ください。
ただし、高度管理医療機器ですので適切に使用し、定期的に診察を受けていただく必要があります。オルソケラトロジーは自由診療で行っています。当院ではメニコンオルソKを使用しています。

低濃度アトロピン点眼(リジュセアミニ点眼液0.025%)
アトロピン点眼は、毛様体筋の調節を減らし、瞳を大きく広げる効果がある目薬で、斜視や弱視の診断や治療によく使われています。
作用機序はいまだにわかっていないことが多いのですが、このアトロピン点眼には近視進行を抑制する効果があり、近年の研究で、濃度を希釈した低濃度アトロピン点眼で近視抑制の効果があることがわかりました。低濃度アトロピン点眼は濃度が低いため副作用がほとんどありません。1日1回夜寝る前に点眼するだけでよく、手間もそれほどかかりません。
またオルソケラトロジーレンズと併用することによりさらに近視進行を抑制する報告もあります。
当院では近視が進行している小さなお子さん早期から使用をおすすめしており、リジュセアミニ点眼液0.025%を処方しております。
多焦点ソフトコンタクトレンズ
近視の強い方やオルソケラトロジーレンズが不適応な方に対して、近視進行抑制効果が期待できます。
円錐角膜・角膜形状異常疾患外来
円錐角膜や角膜形状異常疾患(外傷後や感染症後など)では、角膜がなめらかではないため、強い乱視が生じ、通常のソフトコンタクトレンズや眼鏡では視力が出ないことが多いです。特に円錐角膜は角膜の中央部分の厚みが薄くなり角膜が円錐型にとんがってしまう病気です。
思春期に発症することが多く、徐々に進行し30歳をすぎたあたりで進行が停止すると言われています。近年では約千人に1人といわれています。通常は両目に発症しますが、左右の目で進行の程度に差があることが多いです。
原因は今のところ不明ですが、危険因子として若くアトピー性皮膚炎がありよく目をこする方といわれています。初期では診察だけで発見するのは難しく、乱視の値が多く、視力が出にくいなどで見つかることが多い病気です。その後進行すると角膜が前方に突出することにより、角膜のゆがみ(乱視)がさらに強くなり視力が低下します。特に突出が進行すると突然の眼の痛みと白い混濁が出現する急性水腫になります。診断には角膜形状解析装置が有用です。
当院では、これまでの眼科的検査では行えなかった、角膜、隅角、虹彩などの断層面の観察や立体構造の数値的解析が行える最新の前眼部三次元画像解析を導入して円錐角膜の早期診断や経過をみることができます。治療は円錐角膜の程度は様々で、突出が軽度であれば眼鏡やソフトコンタクトレンズの装用で良好な視力を得られます。
しかし突出が進行するとこれらでは良好の視力が得られなくなりハードコンタクトレンズの適応となります。円錐角膜に加えて、外傷後や感染症後に生じた角膜形状異常疾患に対しても、ハードコンタクトレンズが有効です。
ただし、ハードコンタクトレンズが痛くて装用ができない方には強膜レンズの処方も可能です。乱視がひどく視力が出にくい方は一度角膜の検査をおすすめします。
ドライアイ外来
ドライアイとは、エアコンやパソコン、スマートフォン、コンタクトレンズ、加齢などによって発症する疾患です。近年患者数は2200万人まで増え続けており、「目の現代病」とも呼ばれています。
涙には水と油など、多くの成分が含まれています。目を保護するのに必要な涙の量が足りなくなる、または涙に含まれている物質のバランスが悪くなることで、涙が均等に行き渡らなくなった結果、目の表面に傷がついてしまいます。
当院では、ドライアイ専門の検査機器を用いて、ドライアイの原因を細かく探ることが可能です。
ドライアイの原因は?
まず涙には、水と油など様々な成分が含まれています。それぞれの成分が足りなくなる、質が変わることで涙が乾きやすくなり、症状が現れるのです。
水の成分が不足するタイプ
加齢と共に、涙の水分を生成する涙腺の生成機能が衰えたり、全身疾患によって涙腺に炎症が起こったりすることで、涙の水分量が減るタイプです。涙の水分量がかなり少ない場合は、「シェーグレン症候群」という全身の炎症性疾患が隠れている恐れがありますので、血液検査で確認する必要があります。
油が不足するタイプ
油が分泌される組織である「マイボーム腺」の働きが落ちることで起こります。マイボーム腺はまぶたのふちにある器官で、常に油を分泌して涙の蒸発を防いでいます。マイボーム腺機能不全になると、ドライアイの症状が引き起こされやすくなります。
眼感染症外来
角膜炎や結膜炎などの眼感染症疾患は、めやにや充血などの症状を引きおこし、痛みや視力低下が生じます。
結膜炎とは、その結膜が赤く充血して、炎症を起こしてしまう疾患です。バイキンなどで発症する細菌性結膜炎、ウイルス性結膜炎、アレルギー反応として起こるアレルギー性結膜炎など、多岐にわたります。結膜はまぶたを開けている時、外界からの刺激の影響を受けやすいため、炎症が起こりやすいです。特に赤ちゃんや小さい子供は免疫力がまだ高くないので、細菌が結膜に侵入しやすい傾向にあります。
とくに、アデノウイルスによる結膜炎は、 一般的に、「はやり目」と呼ばれている疾患です。夏に発症者が増える傾向があります。人から人へとうつり、感染してから約5~7日経った後に、結膜炎の症状が現れます。発症した時に、風邪を引くことが多く、症状は2週間ぐらいで治まります。重篤な場合は、黒目(角膜)が濁ってしまう可能性もあります。
ウイルスを死滅させる点眼薬はありません。感染力が強いため、的確に診断して、感染対策をすることが重要です。角膜炎とは、汚れたコンタクトレンズや外傷によって、 目の表面の傷からばい菌が侵入して、目の表面に感染し、角膜が白くなる疾患です。細菌やカビ(真菌)に加えて、アカントアメーバやヘルペスウイルスによって引き起こされます。
アカントアメーバは、洗面所などの水場に存在する原虫で、環境中にはどこにでもいます。コンタクトレンズやレンズケースが細菌感染すると、細菌を餌とするアメーバも増殖しやすくなります。
その結果、コンタクトレンズにアメーバが汚染し、目の表面にも感染症を起こします。非常にまれな疾患なので、診断もむずかしいことがあります。
アカントアメーバ角膜炎は早期診断、早期治療開始が重要です。ヘルペスウイルスは皮膚だけでなく、目にも悪さをします。
特に角膜に出てくると、視力低下などの症状を引き起こします。角膜ヘルペスの診断は典型例ですと比較的簡単ですが、何度も繰り返している症例などは分かりにくいことが多いです。
患者さんによっては特定の季節で出てくる(冬が比較的多いです)方もいます。